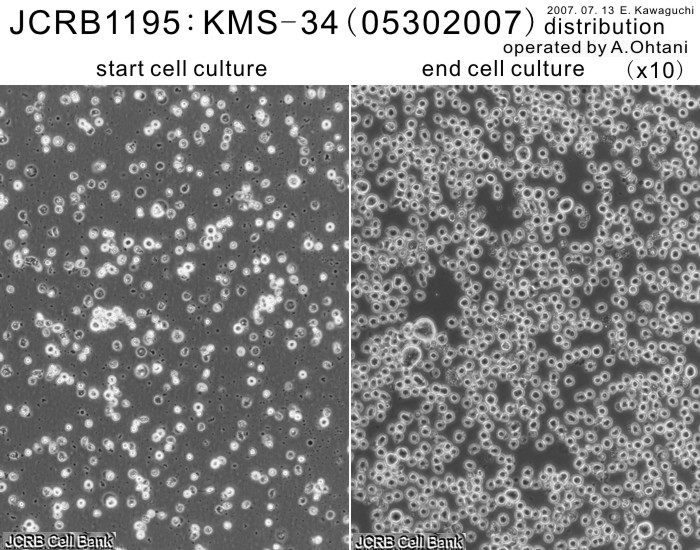

JCRB1195 KMS-34
Cell information
Cell type:general cells (View Pricing Information)
| JCRB No. | JCRB1195 | Cell Name | KMS-34 |
|---|---|---|---|
| Profile | human myeloma cell line. | Other Name | KMS34 |
| Animal | human | Strain | |
| Genus | Homo | Species | sapiens |
| Sex | F | Age | 60 |
| Identity | available | Tissue for Primary Cancer | hemo-lymphocytic |
| Case history | Metastasis | Yes | |
| Tissue Metastasized | Genetics | t(4;14)(p16.3;32.3) | |
| Life Span | infinite | Crisis PDL | |
| Morphology | lymphocyte-like | Character | small round-cell morphology, part is multinucleate cell. |
| Classify | tumor | Established by | Otsuki, T. |
| Registered by | Otsuki, T. | Regulation for Distribution | |
| Comment | Year | 2006 | |
| Medium | RPMI1640 medium with 10% featal bovine serum. | Methods for Passages | Subculture twice a week by dilution(1/3). |
| Cell Number on Passage | 50000 cells / mL | Race | Japanese |
| CO2 Conc. | 5% | Tissue Sampling | pleural effusion |
| Tissue Type | myeloma pleural effusion infiltration(IgAk) |
| Detection of virus genome fragment by Real-time PCR | |||||||||
|---|---|---|---|---|---|---|---|---|---|
| Detected DNA Virus | tested | Detected RNA Virus | tested | ||||||
| CMV | - | parvoB19 | - | HCV | - | HTLV-1 | - | ||
| EBV | - | HBV | - | HIV-1 | - | HTLV-2 | - | ||
| HHV6 | - | HTLV-1 | - | HIV-2 | - | HAV | - | ||
| HHV7 | - | HTLV-2 | - |
-/negative. +/positive. nt/not tested. (positive (+) does not immediately mean the production of infectious viral particles.) |
|||||
| BKV | - | HIV-1 | - | ||||||
| JCV | - | HIV-2 | - | ||||||
| ADV | - | HPV18 | - | ||||||
| Notes | |||||||||
| Reference | |
|---|---|
| Pubmed id:15491288 | Expression of protein gene product 9.5 (PGP9.5)/ubiquitin-C-terminal hydrolase 1 (UCHL-1) in human myeloma cells. Otsuki T,Yata K,Takata-Tomokuni A,Hyodoh F,Miura Y,Sakaguchi H,Hatayama T,Hatada S,Tsujioka T,Sato Y,Murakami H,Sadahira Y,Sugihara T Br J Haematol. 2004 Nov;127(3):292-8 |
| Pubmed id:11886382 | Interleukin 10 abolishes the growth inhibitory effects of all-trans retinoic acid on human myeloma cells. Otsuki T,Yata K,Sakaguchi H,Kurebayashi J,Matsuo Y,Uno M,Fujii T,Eda S,Isozaki Y,Yawata Y,Yamada O,Wada H,Sugihara T,Ueki A Br J Haematol. 2002 Mar;116(4):787-95 |
| Images |
|---|
![]() ![]() ![]() ![]() ![]() ![]() ![]() ![]() ![]() ![]() ![]() ![]() ![]() ![]() ![]() |
LOT Information
Viability/Growth rate/Cell number are represented as actual values measured at lot presentation in JCRB, but are not guaranteed values. Additionally, the doubling time is a rough value measured during passages.| Cell No. | JCRB1195 | Cell Name | |
|---|---|---|---|
| LOT No. | 02222010 | Lot Specification | distribution |
| Medium | RPMI 1640 medium with 10% fetal bovine serum (GIBCO Cat. # 10099) | Temperature | 37 C |
| Cell Density at Seeding | 4.2 - 6.2 x 10^5 cells/ml | Methods for Passages | Dilution |
| Doubling Time | approx. 52 hrs | Cell Number in Vial (cells/1ml) | 1.6 x 10^6 |
| Viability at cell freezing (%) | 70.0 | Antibiotics Used | free |
| Passage Number | Unknown (5 at bank) | PDL | |
| Sterility: MYCOPLASMA | - | Sterility: BACTERIA | - |
| Sterility: FUNGI | - | Isozyme Analysis | Confirmed as human by NP, G6PD (type B), MD. |
| Chromosome Mode | Chromosome Information | ||
| Surface Antigen | DNA Profile (STR) | ||
| Adhesion | No | Exoteric Gene | |
| Medium for Freezing | 10% DMSO, 20% FBS - RPMI 1640 | CO2 Conc. | 5% |
| Viability immediately after thawing (%) | Additional information |
| Cell No. | JCRB1195 | Cell Name | KMS-34 |
|---|---|---|---|
| LOT No. | 05302007 | Lot Specification | distribution |
| Medium | RPMI1640(GIBCO) with 10% heat inactivated fetal bovine serum(Hyclone GRD0051) | Temperature | 37 C |
| Cell Density at Seeding | 3.8x10^5 cells/ml | Methods for Passages | dilution |
| Doubling Time | NT | Cell Number in Vial (cells/1ml) | 4.4x10^6 |
| Viability at cell freezing (%) | 80.2 | Antibiotics Used | free |
| Passage Number | p2* | PDL | NT |
| Sterility: MYCOPLASMA | - | Sterility: BACTERIA | - |
| Sterility: FUNGI | - | Isozyme Analysis | NT |
| Chromosome Mode | NT | Chromosome Information | NT |
| Surface Antigen | NT | DNA Profile (STR) | D5S818:12 D13S317:8 D7S820:10,11 D16S539:10,13,14 VWA:14 TH01:7,9 AM:X TPOX:8,9 CSF1PO:12 |
| Adhesion | No | Exoteric Gene | NT |
| Medium for Freezing | Cell Banker:BLC-1(Nihon Zenyaku Industries) | CO2 Conc. | 5 % |
| Viability immediately after thawing (%) | Additional information |
| Images |
|---|
![]() ![]() ![]() ![]() ![]() ![]() ![]() ![]() |
| Cell No. | JCRB1195 | Cell Name | KMS-34 |
|---|---|---|---|
| LOT No. | 06052015 | Lot Specification | distribution |
| Medium | RPMI1640 medium with 10% featal bovine serum (FBS; GIBCO Cat. # 10091). | Temperature | 37 C |
| Cell Density at Seeding | 1 - 3 x 10^5 cells/mL | Methods for Passages | Simple dilution (suspension culture). |
| Doubling Time | 33 - 84 hrs | Cell Number in Vial (cells/1ml) | 1.2 x 10^6 |
| Viability at cell freezing (%) | 70.0 | Antibiotics Used | free |
| Passage Number | Unknown (14 at bank) | PDL | |
| Sterility: MYCOPLASMA | - | Sterility: BACTERIA | - |
| Sterility: FUNGI | - | Isozyme Analysis | Confirmed as human by NP, G6PD (type B), MD. |
| Chromosome Mode | Chromosome Information | ||
| Surface Antigen | DNA Profile (STR) | ||
| Adhesion | No | Exoteric Gene | |
| Medium for Freezing | 10% DMSO, 20% FBS - RPMI1640 | CO2 Conc. | 5% |
| Viability immediately after thawing (%) | 70.0 | Additional information |
| Cell No. | JCRB1195 | Cell Name | KMS-34 |
|---|---|---|---|
| LOT No. | 09272021 | Lot Specification | distribution |
| Medium | RPMI 1640 medium with 10% fetal bovine serum (FBS; Biowest Cat. # S1820-500) | Temperature | 37 C |
| Cell Density at Seeding | 1.5 - 2.0 x 10^5 cells/mL | Methods for Passages | Simple dilusion (suspension culture). |
| Doubling Time | approx. 31 hrs. | Cell Number in Vial (cells/1ml) | 3.7 x 10^6 |
| Viability at cell freezing (%) | 92 | Antibiotics Used | fre |
| Passage Number | Unknown (5 at bank) | PDL | |
| Sterility: MYCOPLASMA | - | Sterility: BACTERIA | - |
| Sterility: FUNGI | - | Isozyme Analysis | |
| Chromosome Mode | Chromosome Information | ||
| Surface Antigen | DNA Profile (STR) | ||
| Adhesion | No | Exoteric Gene | |
| Medium for Freezing | 10% DMSO, 20% FBS - RPMI1640 | CO2 Conc. | 5% |
| Viability immediately after thawing (%) | 90 | Additional information |